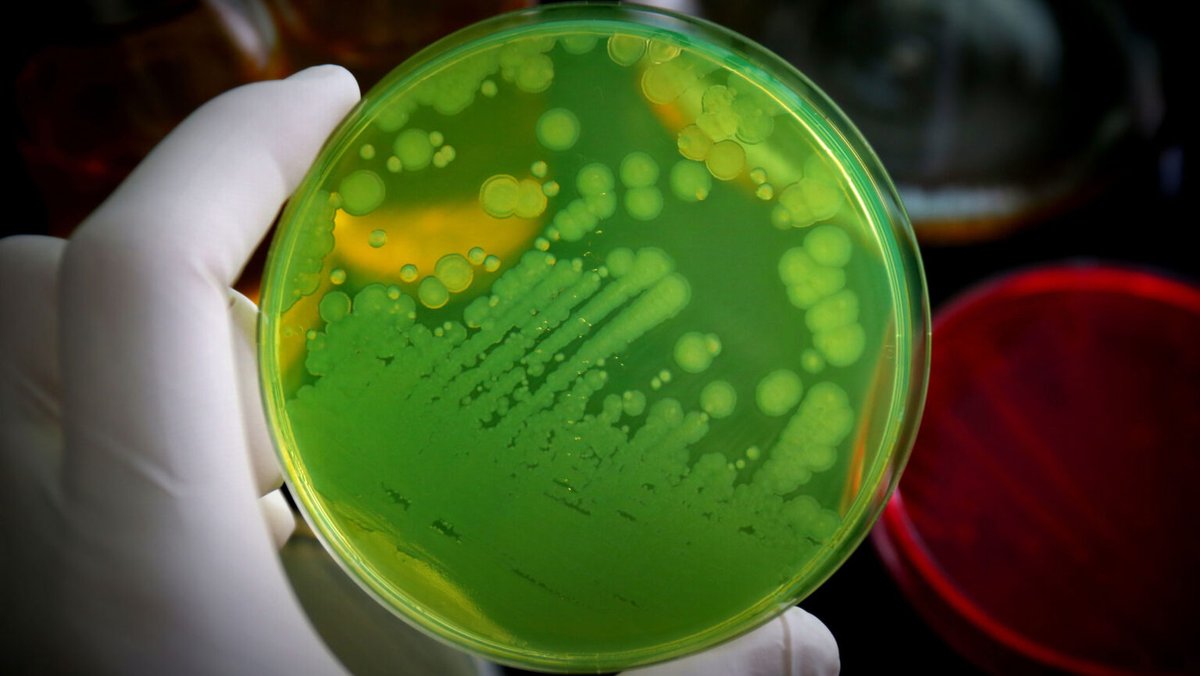
Berkeley Bioengineer tweet media

Berkeley Bioengineer
917 posts


Berkeley Bioengineer
@BerkeleyBioE
Official UC Berkeley Department of Bioengineering - news, events, astounding research, awesome students.
Berkeley, CA Katılım Nisan 2013
45 Takip Edilen2.5K Takipçiler
Berkeley Bioengineer retweetledi

It’s official: UC Berkeley Engineering has a new dean!
Mark Asta, a distinguished materials scientist and a UC Berkeley faculty member for more than 15 years, will lead our college after a competitive national search. bit.ly/4sSMsIc
English

New work from @arkin_lab, funded by the HHS, have engineered colonies of bacteria that can be inhaled to crowd out pathogenic bacteria without antibiotics. @Cal_Engineer Learn more at bit.ly/3YCNuug
English

Congratulations to bioengineering MD/PhD candidate Alice Tang, named to the 2026 Forbes 30 Under 30!
forbes.com/30-under-30/20…

English

Profs Paul Adams, Adam Arkin, Patrick Hsu & Jay Keasling made the Clarivate 2025 Highly Cited Researchers list! clarivate.com/highly-cited-r…

English

Published today in @natBME, Healy and Murthy labs' heart-on-a-chip + lipid nanoparticles discovers ways to effectively deliver gene therapies to the heart. engineering.berkeley.edu/news/2025/11/h…

English

Good news for the future of adaptable oat cultivation! Adjunct Taner Sen and colleagues have assembled and annotated 33 wild oat genomes and an atlas of gene expression. sci.news/genetics/oat-p…
English
Berkeley Bioengineer retweetledi

⏳ Only 1 week left! UC Berkeley’s Engineering Leadership Program starts Aug 20.
✅ Apply now: hubs.li/Q03yZ-rc0
🎥 Watch: hubs.li/Q03yZYnB0
🎓 Trusted by Apple, Samsung, Qualcomm & 1,200+ engineers.
#BerkeleyELPP #Leadership #STEM #TechLeadership #Engineering

English

Bioengineer Maria Astolfi is working to bring equity to the sharing of indigenous biomedical knowledge
UC Berkeley@UCBerkeley
PhD student Maria Astolfi, Professor Jay Keasling and colleagues argue for partnerships with indigenous peoples to create a more ethical bioeconomy, one that will sustain indigenous biodiversity and bring these communities into science as equal partners. news.berkeley.edu/2025/04/30/ind…
English

Congratulations Professor Phil Messersmith, named a 2024 Fellow of AAAS!
tinyurl.com/2025aaasbioe

English

You did it! BIG THANK YOU to over 40 donors who gave to BioE today and unlocked our two matching gifts - you're the best! Go Bears!
lnkd.in/gbq4qWXY
#CalBigGive #FundFutureEngineers

English

Less than 8 hours left to unlock over $50,000 in matching gift for BioE! lnkd.in/gbq4qWXY
Together we make a brighter future for our students and the world. #CalBigGive #FundFutureEngineers

English
Berkeley Bioengineer retweetledi

🌟 Big Give is now LIVE! Consider supporting a group of passionate young scientists running experimental teams, training initiatives, and building a synbio community by students FOR students 🧑🔬
bit.ly/igem-give25
#CalBigGive #iGEMBerkeley #bioengineering #syntheticbiology

English
Berkeley Bioengineer retweetledi

#iGEMBerkeley deserves Big Give love because of all the amazing opportunities in bioengineering and synthetic biology our students get to participate in!
Donate at bit.ly/igem-give25 today!
#CalBigGive

English

Help BioE unlock over $50,000 in matching gifts with your gift of any size! tinyurl.com/bioebiggive
#BerkeleyBioE #CalBigGive #FundFutureEngineers

English

Join us! Bioengineering is recruiting a part-time lecturer:
bioeng.berkeley.edu/people/lecturer
English


